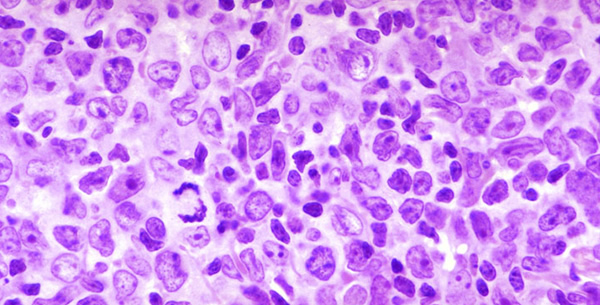
Lymphoma Lymphoma

Definicija:
Limfomi su maligne bolesti limfo-retikularnog sistema, koga ćine ga limfocitne i monocitno-makrofagne ćelije, a koji je baza celularnog i humoralnog imuniteta.
Etiopatogeneza:
Na njih otpada 2% malignih neoplazmi. U svim zemljama se bilježi godišnji porast učestalosti limfoma za 5-10%.
U limfome spada čitav niz , često međusobno veoma razlih oboljnja. Heterogenost maligni limfoma potiče od različitosti histoloških subtipova, nodalne ili ekstranodane lokaizacije, kapaciteta diseminacije, doba i opšteg zdravstvenog stanja pacijenta. Na osnovu patohistološke slike, načina rasta, biologije bolesti, kao poseban entitet se izdvaja Hodgkinova bolest (Morbus Hodgkin, MH), dok se ostali svrstavaju u veliku i raznorodnu grupu takozvanih Non-Hodgkin limfoma (NHL). Na MH otpada 40% malignih limfoma, a 60% na NHL.

Be the first to comment